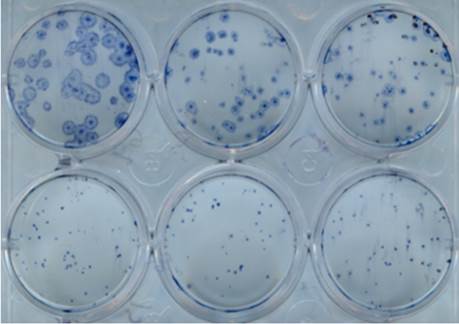

Using antibodies to target neuraminidase, the less abundant antigen on the surface of the influenza B virus
Published in Microbiology
The paper in Nature Microbiology is here: http://go.nature.com/2xZbtql

On September 28, 2017, the 2017-2018 influenza vaccination campaign was launched during a press conference in Washington, D.C. Despite the annual push for vaccination and the existence of antivirals, the influenza virus remains a major public health burden, causing an estimated 140,000 to 710,000 hospitalizations and 12,000 to 56,000 deaths in the U.S. every year since 2010, according to the Centers for Disease Control. As these annual epidemics of influenza are caused by influenza A viruses (IAVs) and influenza B viruses (IBVs), seasonal vaccines target two IAVs and one (or two) IBVs that are predicted to be the major circulating strains. These vaccines have to be reformulated every year, and years during which the vaccine strains and the circulating strains are mismatched result in higher disease burden. Historically, of the two most abundant influenza virus glycoproteins, hemagglutinin (HA) has been the focus of research as the immunodominant antigen. However, we focused on the less studied neuraminidase (NA) in our paper.
We analyzed murine monoclonal antibodies (mAbs) against the NA and found five that demonstrated broad binding, NA enzyme inhibition, in vitro antibody-dependent cell-mediated cytotoxicity, and in vivo protection (prophylactically and therapeutically) against representative viruses belonging to both circulating IBV lineages that span more than 70 years of antigenic drift. With the use of negative-stain electron microscopy with three-dimensional reconstruction, we were able to visualize recombinantly expressed NA in complex with the antigen-binding (Fab) fragment of two of these mAbs; this allowed for an approximation of the antibody binding footprint (the portion of the NA surface where the antibody binds). The amino acids that make up the binding footprints of these two antibodies are highly conserved across all IBVs. Critical residues were then identified by serial passaging IBVs in the presence of the antibodies until escape mutants that could grow in the presence of antibody were recovered. While all five mAbs demonstrated NA inhibition, only one mAb possessed a critical residue directly adjacent to the enzymatic site of NA, demonstrating that more distant binding can still inhibit NA activity.
The only approved antivirals in our arsenal that work against currently circulating influenza viruses are small molecule NA inhibitors, including oseltamivir. Another exciting finding of our study involved comparing oseltamivir to an anti-NA mAb. In our mouse model, we found that one therapeutic dose of one of the mAbs was more protective than twice daily dosing of oseltamivir for 6 days, the current standard of care for influenza virus infection. In addition to having activity as an enzyme inhibitor, mAbs also can stimulate effector functions, as we showed with an in vitro reporter assay measuring antibody-dependent cell-mediated cytotoxicity. Targeting broadly protective NA epitopes may provide us with new therapeutics and also inform future vaccine strategies.
Please sign in or register for FREE
If you are a registered user on Research Communities by Springer Nature, please sign in